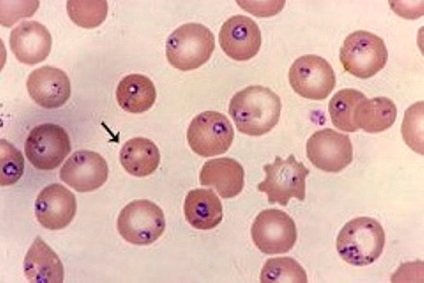

Ehrlichiosis a kutyák és emberi okai
Ehrlichiosis utal fertőző betegségek, szerek, amelyek Rickettsia. A fő hordozó kullancs Rhipicephalus sanguineus fertőzni az állat alatt egy falatot. A betegségre jellemző elváltozások a keringési rendszer, a máj, a lép és más belső szerveket. Abban az esetben, egy átmeneti krónikus formájában visszafordíthatatlan változások a csontvelő, halálhoz vezető.

típusú kórokozók
Ehrlichia nemzetség tartozik több faj Ehrlichia, amelyek különböznek egymástól lokalizációt a szervezetben kutyák. Ezek közé tartoznak:
- Canis behatol a citoplazmába leukociták, és egy pusztító hatás;
- Ewingii parazita csak granulociták;
- E. risticii, E. Platys és E. Sennetsu befolyásolják a vérlemezkék;
- Chaffeensis látens formában ehrlichiosis.
Ezek a kórokozók veszélyes az emberre. Bekerülni a véráramba a harapás kullancsok, vagy a nyers hal, az általuk okozott érrendszeri károsodás, mérgezés jeleit, leukopenia, növekedése parenchymás szervek, és szövődmények esetén - belső vérzés és agyhártyagyulladás. humán ehrlichiosis gyógyítható antibiotikumokkal. Ha a kezelést alatt kezdeményezett akut stádiumában a betegség, a helyreállítási fordul elő 100% -ában.

Jelek az emberi fertőzés Ehrlich
A transzmissziós mechanizmus
Rickettsiae okozva ehrlichiosis, élősködnek a sejtek a hám a gyomor-bél traktus kullancsok és vérszívó rovarok, mint a tetvek és bolhák ellen.
Első őket a szervezetbe emlősök fordul nyállal alatt egy falatot. Néhány állat, ez nem egy megnyilvánulása a betegség tüneteit, és előfordul látens formában. De ők maguk válnak hordozók Ehrlichia, és képes megfertőzni másokat.
A nőstények a kullancsok és bolhák továbbítja kórokozók utódaiknak keresztül fertőzött tojás. De melegvérű állatok ehrlichiosis nem kerül továbbításra a méhben.
fázisában a betegség
Bejutását a kórokozó a kutya testén, hogy a tünetek zajlik 1-8 hét. Ebben az időszakban, rikettsiák behatolnak a fehérvérsejtek és elkezdenek szaporodni. Mivel a vér áramlását, azok végrehajtása az egész szervezetben, lokalizált a májban, a lépben, a vese, nyirokcsomók. Ez nagyon ritkán fordul elő károsíthatja az idegrendszert és a tüdőt.

Vasculitis - szubkután kapcsolatos vérzések a megsemmisítése érfalak
kutyák Ehrlichiosis fordul három szakaszból áll:
- Az akut szakaszban. Ebben az időszakban megnő a parenchymás szervek és beteg nyirokcsomók. A megsemmisítése nagyszámú vérsejtek bekövetkezik thrombocytopenia, leukopenia, és a vérszegénység. érfalak fokozatosan elvékonyodnak, begyulladnak és elkezdi lebontani. Ez ahhoz vezet, hogy a tünetek megjelenése vasculitis (többszörös petechiák).
- Látens színpadon. Jön a látszólagos javulás, mint a külső jelei már kevésbé látható. Ez akkor fordul elő növekedése miatt az ellenanyag-termelés a csontvelő sejtek. Ezek azonban nem képesek önállóan teljesen tönkreteszik a kórokozók, így a betegség mozog a következő fázis.
- Krónikus fázisban. Ebben az időszakban, vannak hibák a csontvelőben, amely nem képes reprodukálni a szükséges mennyiségű leukociták és vörösvértestek. A kritikus csökkenése ezek a mutatók a szervezetben kezdődik visszafordíthatatlan folyamatokat, ami végül a halál.
Ehrlichiosis kutyát érint, kezdve két hónapos korban, és befejezve a régi kor. De legfőképpen azt hajlamos egyéneknél 5 év alatti, nemtől és rock kiegészítők.
Az első jelei a betegség
Az első tényező, amely figyelmezteti a kutya tulajdonosok, a jelenléte a szervezetben a pet ragadt kullancs. Az eltávolítás után egy pár hétig, szükség van az állapot követésére az állat, és az első jele a rossz egészségi fel a kapcsolatot az állat-egészségügyi technikus.

Atka - a fő vektora ehrlichiosis
De a tény az, hogy a jelenléte a parazita a kutya testét nem mindig lehet kimutatni. Ez annak a ténynek köszönhető, hogy a kullancsok a hímek szurdok a vér 2-3 óra, majd eltűnnek, mielőtt megfertőzi az állatot.
Ezért még nem mutatta ki az ízeltlábúak adatok, az esemény a következő tünetek gazdik kell riasztani:
- étvágytalanság vagy teljes elutasítása a takarmány;
- hirtelen súlyvesztés;
- letargia;
- toxicitás jelei;
- láz;
- a megjelenése a bőrön a zúzódások vagy látható nyálkahártyák;
- ésszerűtlen túlzott vérzés;
- rendezetlenség.
Mindezt meg lehet ok az azonnali kezelést az orvos, aki megvizsgálja a beteget, és elküldi a vért a laboratóriumba, hogy erősítse meg a diagnózist ehrlichiosis.
fertőzöttség leukocita
A vizsgálat során, amellett, hogy a fenti tünetek észlelhetők:
- duzzadt nyirokcsomók;
- cianózis a nyálkahártya;
- légszomj;
- ataxia;
- zavar a központi idegrendszert.
A végső diagnózis felállítása után a szerológiai vérvizsgálatot, hogy zárja ki betegségek, mint például:
- brucellózis;
- szisztémás lupus erythematosus;
- myeloma multiplex.
A cikk fül atkák kutyák: tünetek és a kezelés lehet tanulni, hogyan kell segíteni az állat, amikor otodektoz.
Ezt megelőzően a hozzárendelt tüneti kezelést és az antibiotikum-terápiát. A legtöbb esetben a kedvező prognózist, elpusztul, és végül teljesen kiürül. Fokozatosan helyreáll a munka minden szervek és rendszerek.
Ennek hiányában a megfelelő kezelés történhet látható javulás amelyek látszólag helyreállítást. Azonban ez nem az. Ehrlichiosis válik krónikus stádiumban, amikor a prognózis a kezelés a legtöbb esetben miatt kedvezőtlen, hogy az elején visszafordíthatatlan változások a csontvelőben.
Manifesztációk krónikus szakaszában
A következő tünetek jelenhetnek meg hirtelen a háttérben jelentős javulást az állapota a kutya:
- erős vérzés;
- gyors egyidejű növekedése sok a nyirokcsomók;
- anaemia (sápadtság) látható nyálkahártyák;
- végtagi duzzanat;
- herezacskó duzzanat is előfordulhat férfiaknál;
- vérzések a retinában, retinaleválás, vagy elhomályosodását a szaruhártya, látásvesztés;
- görcsök.

Bőrpír nyálkahártya - flag krónikus szakaszában
A tapintással érzékelni képes erős növekedése a máj és a lép.
Hogyan kezeljük
Az akut fázisában ehrlichiosis jól reagál az antibiotikumos kezelés, hogy megölik a parazitákat. Értük, és meghatározza az adagot csak egy állatorvos.
Glükokortikoid és szteroid gyógyszereket írnak fel a karbantartás és a teljesítmény fokozása csontvelőben.
A gyógyszerek, amelyek a szokásos tüneti kezelés:
- támogatják a szív- és érrendszer;
- javítja az étvágyat;
- csökkenti a tüneteket a mérgezés;
- Van egy vérzéscsillapító hatása.
Súlyos esetekben, egy beadását elektrolit oldatok, transzfúziós vér vagy vérlemezkék.
Műtét ritkán használják a nagy degeneratív folyamatok csontvelő vagy parenchymás szervek.
megelőzés
Prevent Ehrlichiosis lehetséges, ha:
- Kezelése kutyák atkaölő készítmények előtt séta.
- Ne járni állataik a nyilvános helyeken kullancsok. különösen tavasszal és ősszel.
- Időben megöli a bolhákat és megakadályozza a további megjelenését.
- Kerülni kell az érintkezést a vadon élő és beteg állatokat.
Ezekkel az egyszerű technikákat, akkor elkerülhető a súlyos betegség, amely azzal fenyeget, nem csak a kutya, hanem a tulajdonos.
Fogyni 32 kg a nyár, mint a csillag a KVN Olga Kartunkova egyszerűen böjt.

Worms bullet „repülni”, ha egy korty vizet isznak 3 csepp.

Kő erekció! A potencia rendben volt, keverjük a természetes víz.